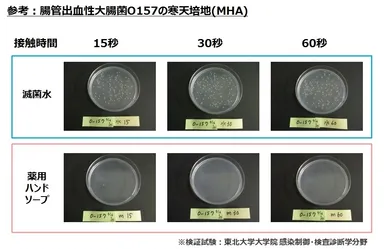
参考：腸管出血性大腸菌O157の寒天培地(MHA)

秋は食中毒予防の盲点の季節!手洗い・消毒の徹底を 30秒以上の薬用ハンドソープとの接触で、 腸管出血性大腸菌O157など主要な食中毒菌が生残しないことを確認
調査・報告
2014年9月19日 14:30『バイ菌・感染症から家族を守る 徹底!手洗いラボ』(事務局:東京都渋谷区、以下 『徹底!手洗いラボ』 http://tearai-lab.com )では、家庭でもできる衛生的な「ハンドソープを使ったしっかり手洗い」を推奨しています。
その一環として、東北大学病院 総合感染症科 検査部のご協力の下、市販のキッチン用の薬用ハンドソープについて、主要な食中毒菌に対する接触時間における殺菌力の検証を行いましたので公表いたします。
検証試験では、腸管出血性大腸菌O157、カンピロバクター、黄色ブドウ球菌など、梅雨から夏にかけて多い細菌性食中毒の原因菌、5種類について調べました。
検証試験の結果、薬用ハンドソープに10の5乗個の菌を添加したところ、15秒の接触で各菌とも多くが殺菌され、30秒以上の接触で、各菌は生残しませんでした。また、今回調べた菌種による殺菌力の差はありませんでした。
食中毒の原因菌が付着しがちな生の肉や魚を触る場合、家族が食中毒を発症した場合、トイレの後など、殺菌力のある薬用せっけんを使用する場合は、30秒以上かけたしっかり手洗いを心がけましょう。
■検証試験概要
<検証したハンドソープ>
『市販のキッチン用の薬用ハンドソープ』
(有効成分:サリチル酸)
<検証した食中毒原因菌>
・腸管出血性大腸菌O157 Escherichia coli O157(臨床分離)
・サルモネラ属菌 Salmonella属(臨床分離)
・黄色ブドウ球菌 Staphylococcus aureus(臨床分離)
・腸炎ビブリオ Vibrio parahaemolyticus(臨床分離)
・カンピロバクター Campylobacter jejuni(臨床分離)
<検証方法>
(1) ハンドソープ、滅菌水それぞれ1mlに10の5乗個の菌を添加
(※腸炎ビブリオのみ5倍の菌量を添加)
(2) 15秒、30秒、60秒間、よく混ぜ、十分に菌と
ハンドソープまたは滅菌水を接触させる
(3) すぐに10mlの滅菌水に100μl入れて希釈(中和)
(4) 100μlを寒天培地(MHA)に塗り拡げる
<検証結果>
『市販のキッチン用の薬用ハンドソープ』に10の5乗個の菌を添加したところ、30秒以上の接触で、各菌は生存しなかった。
※検証試験:東北大学大学院 感染制御・検査診断学分野
■『バイ菌・感染症から家族を守る 徹底!手洗いラボ』とは
『徹底!手洗いラボ』は、インフルエンザウイルス、RSウイルス、そしてノロウイルスなどの感染症や食中毒について、東北大学大学院 医学科研究科 賀来 満夫先生を中心とした感染症学の専門家が小児科医、幼稚園・保育園、企業などと連携しながら、感染症・食中毒の接触感染のリスクと正しい手洗い方法を生活者の方々に伝えていくことを目的に設立された研究所です。
ホームページ: http://tearai-lab.com